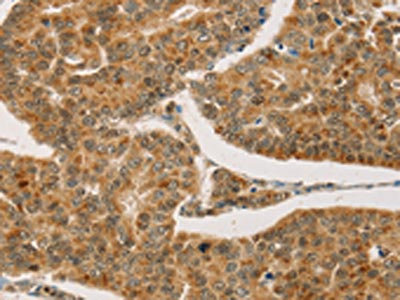

CPA2 Antibody
-
中文名稱:CPA2兔多克隆抗體
-
貨號:CSB-PA561433
-
規(guī)格:¥1100
-
圖片:
-
The image on the left is immunohistochemistry of paraffin-embedded Human liver cancer tissue using CSB-PA561433(CPA2 Antibody) at dilution 1/20, on the right is treated with fusion protein. (Original magnification: ×200)
-
The image on the left is immunohistochemistry of paraffin-embedded Human breast cancer tissue using CSB-PA561433(CPA2 Antibody) at dilution 1/20, on the right is treated with fusion protein. (Original magnification: ×200)
-
Gel: 8%SDS-PAGE, Lysate: 40 μg, Lane: Mouse pancreas tissue, Primary antibody: CSB-PA561433(CPA2 Antibody) at dilution 1/500, Secondary antibody: Goat anti rabbit IgG at 1/8000 dilution, Exposure time: 10 seconds
-
-
其他:
產(chǎn)品詳情
-
Uniprot No.:
-
基因名:CPA2
-
別名:CPA2Carboxypeptidase A2 antibody; EC 3.4.17.15 antibody
-
宿主:Rabbit
-
反應(yīng)種屬:Human,Mouse,Rat
-
免疫原:Fusion protein of Human CPA2
-
免疫原種屬:Homo sapiens (Human)
-
標(biāo)記方式:Non-conjugated
-
抗體亞型:IgG
-
純化方式:Antigen affinity purification
-
濃度:It differs from different batches. Please contact us to confirm it.
-
保存緩沖液:-20°C, pH7.4 PBS, 0.05% NaN3, 40% Glycerol
-
產(chǎn)品提供形式:Liquid
-
應(yīng)用范圍:ELISA,WB,IHC
-
推薦稀釋比:
Application Recommended Dilution ELISA 1:2000-1:5000 WB 1:500-1:2000 IHC 1:50-1:200 -
Protocols:
-
儲存條件:Upon receipt, store at -20°C or -80°C. Avoid repeated freeze.
-
貨期:Basically, we can dispatch the products out in 1-3 working days after receiving your orders. Delivery time maybe differs from different purchasing way or location, please kindly consult your local distributors for specific delivery time.
-
用途:For Research Use Only. Not for use in diagnostic or therapeutic procedures.
相關(guān)產(chǎn)品
靶點詳情
-
基因功能參考文獻:
- This study showed that CPA2 and CPB1 variants are not associated with chronic pancreatitis. PMID: 26316592
- CPMG RD data analysis thus allowed a detailed structural characterization of the ADA2h denatured state under folding conditions not previously achieved for this protein. PMID: 26115097
- Chymotrypsin C is a co-activator of human pancreatic procarboxypeptidases A1 and A2. PMID: 21098023
- changes in zinc ligation promote remodeling of the active site in the zinc hydrolase superfamily PMID: 11743734
- NMR structure of the activation domain PMID: 12538893
- The high-resolution crystal structure and solution NMR structure of AYEdesign show that the experimentally determined backbone and side-chains conformations are effectively superimposable with the computational model at atomic resolution. PMID: 17196978
- we have used one of the best-characterized models for folding and misfolding, the activation domain of procarboxypeptidase A2. The wild type (WT) and three mutants affecting the kinetics of aggregation have been studied by IR from the folded state PMID: 19817500
顯示更多
收起更多
-
亞細胞定位:Secreted.
-
蛋白家族:Peptidase M14 family
-
數(shù)據(jù)庫鏈接:
Most popular with customers
-
-
YWHAB Recombinant Monoclonal Antibody
Applications: ELISA, WB, IHC, IF, FC
Species Reactivity: Human, Mouse, Rat
-
Phospho-YAP1 (S127) Recombinant Monoclonal Antibody
Applications: ELISA, WB, IHC
Species Reactivity: Human
-
-
-
-
-